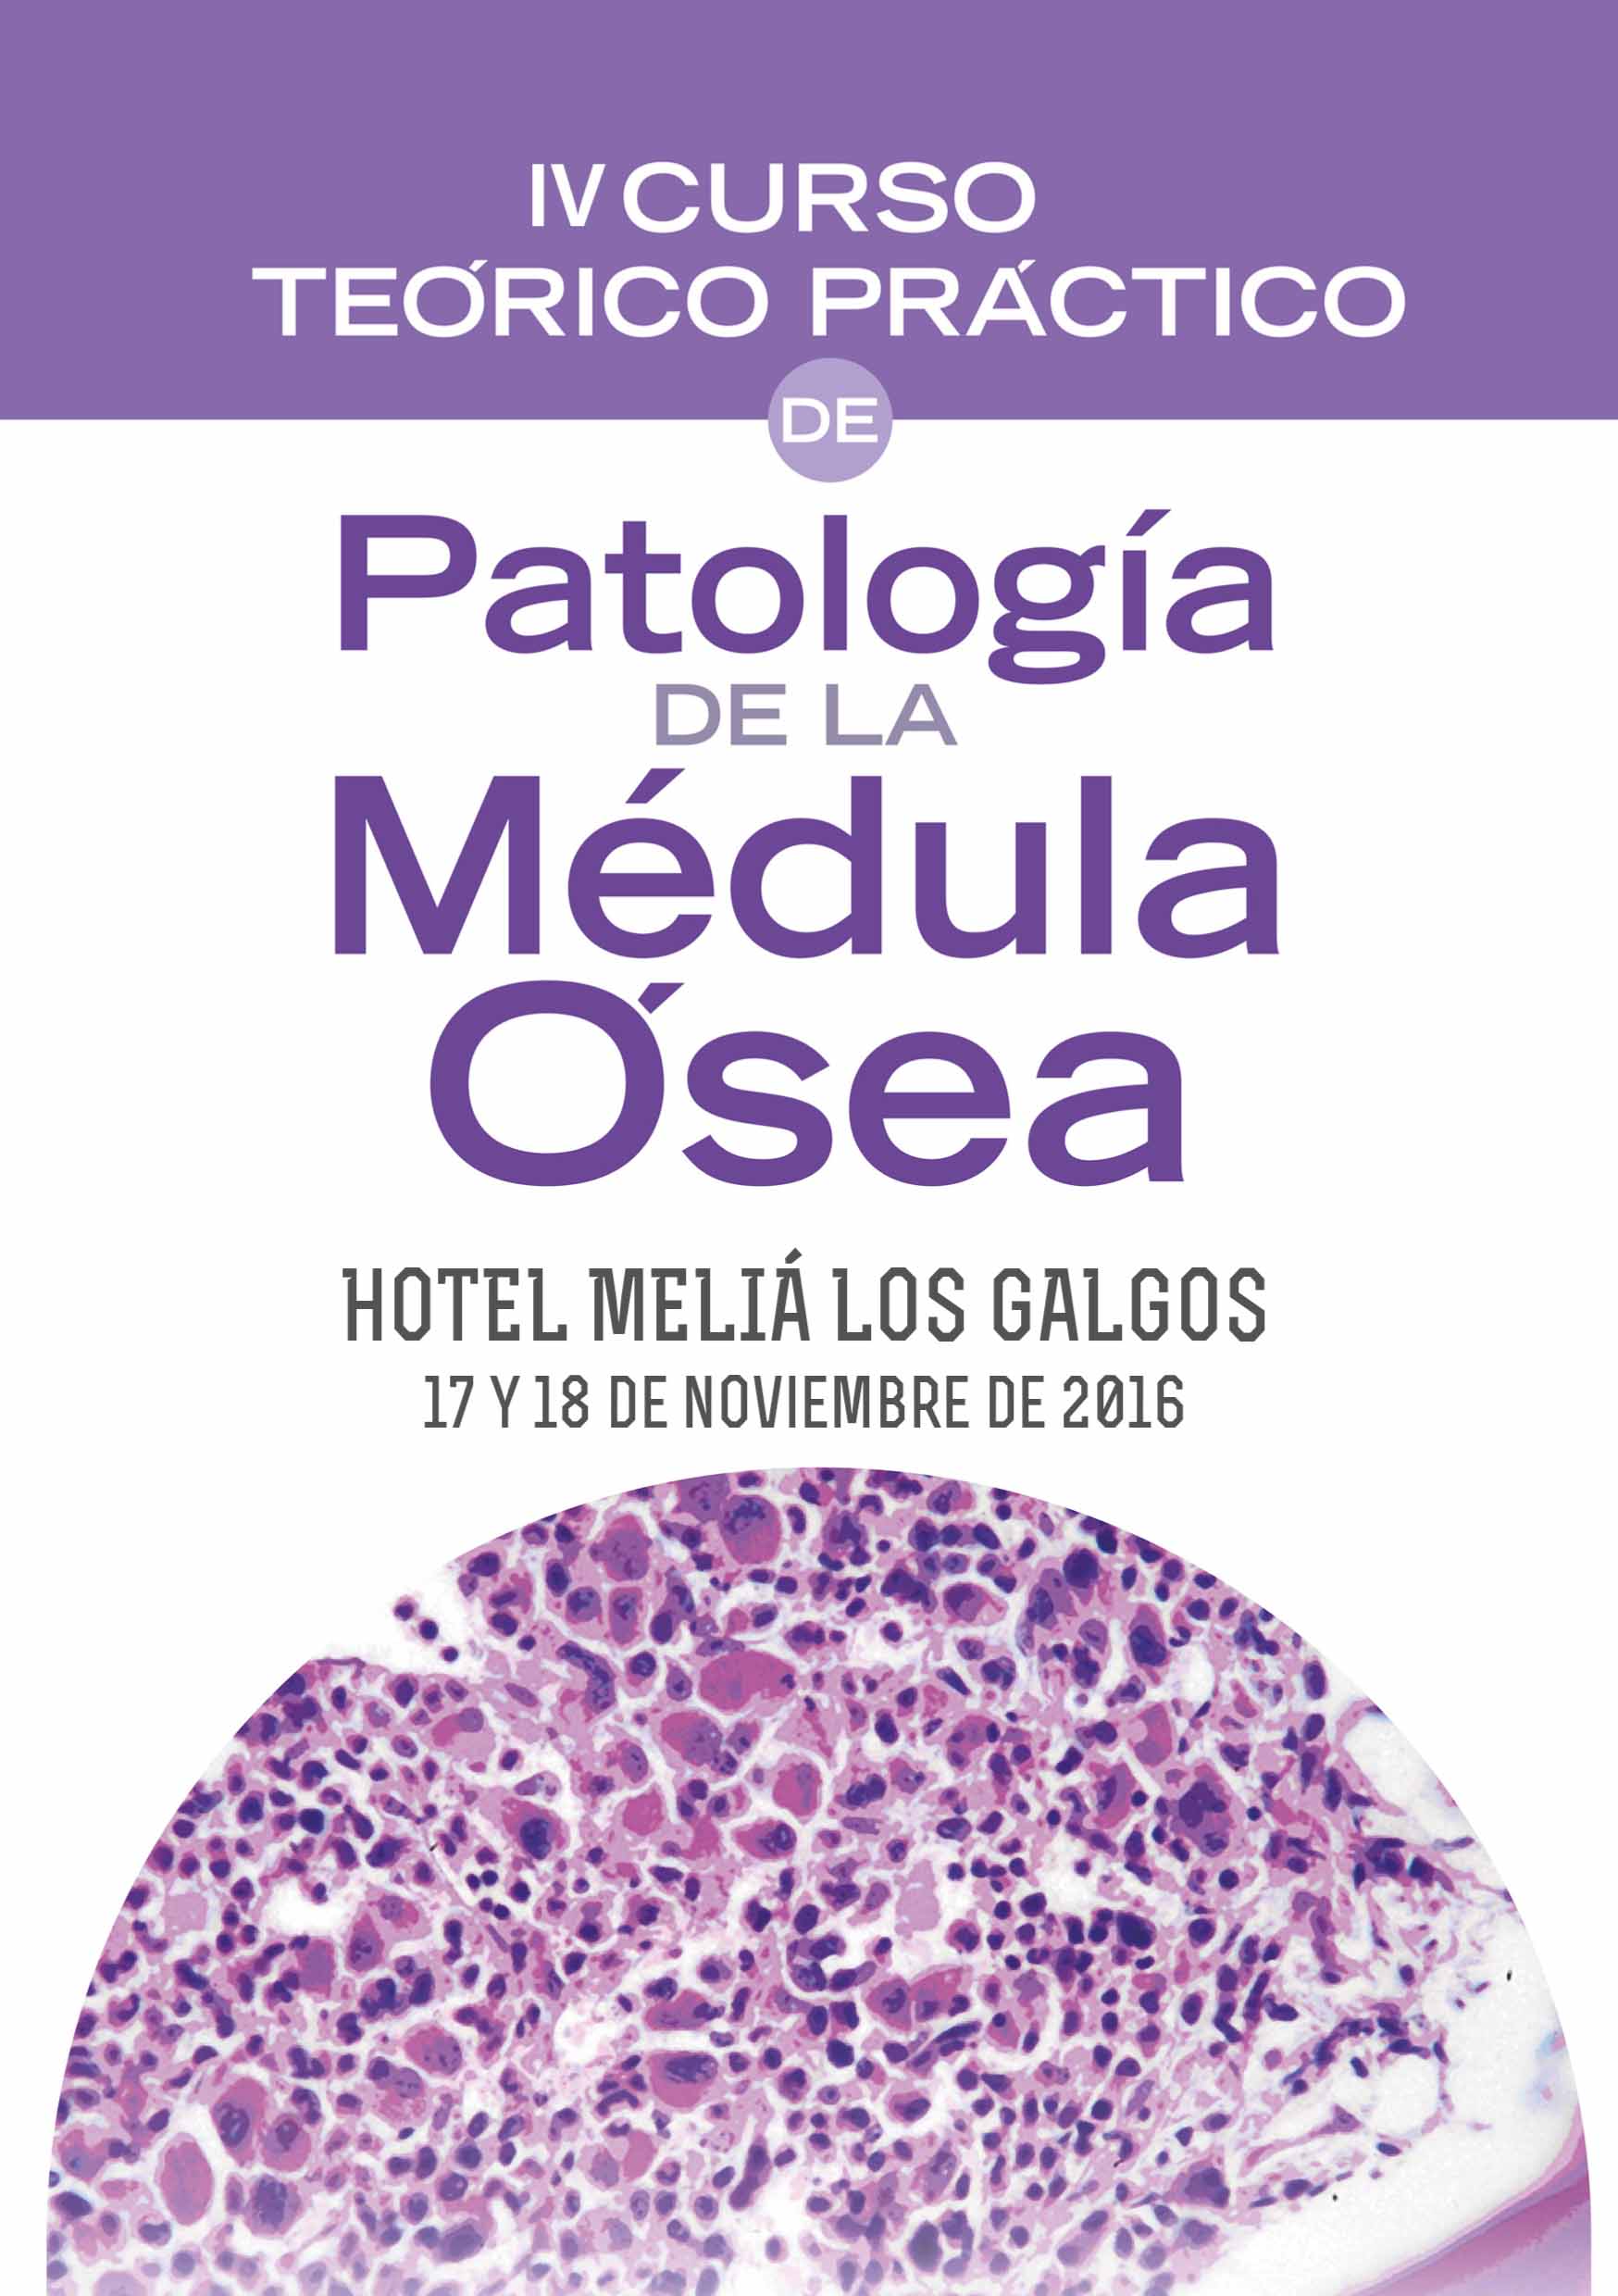

Mantente informado:
Suscríbete a nuestra newsletter.
Un encuentro que conmemoró veinticinco años de compromiso con la investigación, la formación y la atención integral a los pacientes oncohematológicos y sus familias.
25 años impulsando la investigación, la formación, la donación de sangre y médula ósea y apoyando a los pacientes y sus familias
La Fundación Leucemia y Linfoma celebra su 25º Aniversario con un emotivo acto benéfico